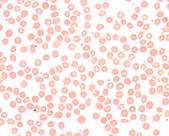

Krankheitsbild: Was ist die Sichelzellkrankheit?
Autor: PD Dr. med. Gesche Riabowol, Redaktion: Ingrid Grüneberg, Freigabe: Dr. med. S. Lobitz, Dr. med. R. Dickerhoff, Prof. Dr. med. U. Creutzig, Zuletzt geändert: 06.05.2024 https://kinderblutkrankheiten.de/doi/e100567
Die Sichelzellkrankheit ist eine erbliche Erkrankung der roten Blutkörperchen (Erythrozyten), die sich auf den ganzen Körper auswirken kann. Erythrozyten werden im Knochenmark gebildet. Sobald sie reif sind, gelangen sie ins Blut. Dort haben sie unter anderem die Aufgabe, lebensnotwendigen Sauerstoff aus den Lungen in alle anderen Körperregionen zu transportieren. Der Sauerstoff ist an den roten Blutfarbstoff, das Hämoglobin, gebunden. Normales Hämoglobin besteht aus zwei verschiedenen Eiweißketten, die man als alpha- und beta-Ketten bezeichnet. Die Art und Weise, wie sich diese Ketten zusammenlagern, bestimmt die räumliche Struktur des Hämoglobins und ist dafür zuständig, dass das Molekül richtig arbeiten kann.
Gesunde rote Blutkörperchen enthalten normales Hämoglobin. Dadurch sind sie rund (siehe Abbildung, schwarzer Pfeil) und geschmeidig, so dass sie problemlos auch durch kleinste Blutgefäße passen und entsprechend zu allen Organen gelangen, um ihre lebenswichtigen Aufgaben auszuführen. Bei der Sichelzellkrankheit ist die beta-Kette im Hämoglobin krankhaft verändert. Man spricht in diesem Fall auch von „Sichelzellhämoglobin“. Wenn Sichelzellhämoglobin nicht mit Sauerstoff beladen ist, verändert es seine Form, und in der Folge verändert sich auch die Form der roten Blutzellen. Sie erinnern an Sicheln, die der Erkrankung ihren Namen gegeben haben (siehe Abbildung, roter Pfeil):

Sichelzellen
Ausstrich von roten Blutzellen eines Patienten mit Sichezellkrankheit. Schwarzer Pfeil: gesundes rotes Blutkörperchen, roter Pfeil: Sichelzelle (© KPOH)
Sichelzellen sind unbeweglicher und sterben früher als gesunde rote Blutkörperchen (Hämolyse). Dadurch kommt es einerseits zur Blutarmut (Anämie) und andererseits zu Verstopfungen der Blutgefäße durch die Sichelzellen. Das führt dazu, dass die betroffenen Körperregionen nicht ausreichend Sauerstoff erhalten. Sauerstoffmangel wiederum hat Gewebeschädigungen zur Folge, und bei einer Gewebeschädigung produziert unser Körper Substanzen, die Schmerzen auslösen. Bei der Sichelzellkrankheit kommt es typischerweise zu Phasen mit starken Schmerzen (Schmerzkrisen) sowie zu Organschädigungen besonders durch verstopfte Blutgefäße im Knochenmark, in den Lungen, im Zentralnervensystem, in der Milz und im Magen-Darm-Trakt. Die schon in den ersten Lebensjahren durch verstopfte Blutgefäße geschädigte Milz ist die Ursache des hohen Risikos für lebensbedrohliche Infektionen bei Sichelzellpatienten.